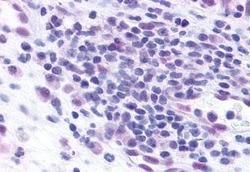
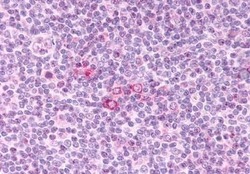

Antibody data
- Antibody Data
- Antigen structure
- References [0]
- Comments [0]
- Validations
- Immunohistochemistry [5]
Submit
Validation data
Reference
Comment
Report error
- Product number
- PA5-33396 - Provider product page

- Provider
- Invitrogen Antibodies
- Product name
- CCR3 Polyclonal Antibody
- Antibody type
- Polyclonal
- Antigen
- Synthetic peptide
- Description
- Percent identity with other species by BLAST analysis: Human, Gorilla, Monkey (100%) Gibbon (94%) Marmoset, Dog, Rabbit (88%) Mouse, Bovine, Hamster, Horse (81%).
- Reactivity
- Human
- Host
- Rabbit
- Isotype
- IgG
- Vial size
- 50 μg
- Concentration
- 1 mg/mL
- Storage
- Store at 4°C short term. For long term storage, store at -20°C, avoiding freeze/thaw cycles.
No comments: Submit comment
Supportive validation
- Submitted by
- Invitrogen Antibodies (provider)
- Main image

- Experimental details
- Immunohistochemistry analysis of CCR3 in Brain, Alzheimers disease (senile plaque). Samples were incubated with CCR3 polyclonal antibody (Product # PA5-33396).
- Submitted by
- Invitrogen Antibodies (provider)
- Main image

- Experimental details
- Immunohistochemistry analysis of CCR3 in human Prostate, Carcinoma. Samples were incubated with CCR3 polyclonal antibody (Product # PA5-33396). Formalin-fixed, paraffin-embedded tissue after heat-induced antigen retrieval.
- Submitted by
- Invitrogen Antibodies (provider)
- Main image
- Experimental details
- Immunohistochemistry analysis of CCR3 in human nasal mucosa, allergic rhinitis. Samples were incubated with CCR3 polyclonal antibody (Product # PA5-33396). Formalin-fixed, paraffin-embedded tissue after heat-induced antigen retrieval.
- Submitted by
- Invitrogen Antibodies (provider)
- Main image

- Experimental details
- Immunohistochemistry analysis of CCR3 in human tonsil. Samples were incubated with CCR3 polyclonal antibody (Product # PA5-33396). Formalin-fixed, paraffin-embedded tissue after heat-induced antigen retrieval.
- Submitted by
- Invitrogen Antibodies (provider)
- Main image
- Experimental details
- Immunohistochemistry analysis of CCR3 in Tonsil, Immunoblasts. Samples were incubated with CCR3 polyclonal antibody (Product # PA5-33396).
 Explore
Explore Validate
Validate Learn
Learn Immunohistochemistry
Immunohistochemistry